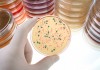
Пять скрытых причин дрожжевой инфекции, или молочницы

Статьи
Happy New Baby: почему Новый год – лучшее время для зачатия
Что скрывать – многие встречают Новый год не только с бенгальскими огнями и салатом оливье, но и с исключительно романтическими настроем. Оно и понятно....
Подготовка к беременности
Как часто надо заниматься сексом паре, которая решила родить ребенка, и сколько времени может уйти на попытки забеременеть? Каковы ваши шансы забеременеть именно в...
Длина сперматозоида влияет на возможность оплодотворения
Американские ученые обнаружили, что большая разница в длине сперматозоидов ухудшает способность к оплодотворению. «По данным Всемирной организации здравоохранения (ВОЗ) оценка способности к оплодотворению должна проводиться...
Какие механизмы помогают выносить беременность?
Американским ученым удалось ответить на давний вопрос, почему иммунная система матери не отторгает плод во время беременности. Работа иммунной системы В норме в ответ на появление...
Подготовка к здоровой беременности
Как подготовиться к беременности? На чем из прошлой жизни придется поставить крест будущей маме? Устраните все препятствия Если вы используете внутриматочный контрацептив – устраните его. ...
Собираетесь забеременеть? Тогда к врачу!
Консультация врача до зачатия даст вам все сведения о предстоящей беременности. Как обычно проходят подобные консультации, и что необходимо знать о вас врачу? Половой...
Как правильно подготовиться к беременности
Собираетесь забеременеть? Распечатайте этот план действий по подготовке к здоровой беременности. План действий Принимайте фолиевую кислоту уже сейчас, не дожидаясь беременности. Это...
Я беременна?
Есть женщины, которые знают, что беременны уже через несколько дней: появляются необычные ощущения в теле. Но большинство из нас ничего не подозревает, пока не...
Беременность и пренатальные витамины
Специально разработанные пренатальные мультивитамины восполняют дефицит любых питательных веществ в рационе матери. В пренатальных витаминах есть фолиевая кислота, железо, кальций. Зачем нужны беременным все...
"Мой кабинет"
Самое интересное на форуме
ПОДПИСАТЬСЯ НА РАССЫЛКУ
Последние просмотренные
Виновата ли кола?
Чем больше исследуется влияние такого популярного напитка, как кола на здоровье человека, тем больше тревожных данных накапливается у ученых. Недавнее исследование, проведенное сотрудниками Копенгагенского...
ЗАПИСАТЬСЯ НА ПРОГРАММУ